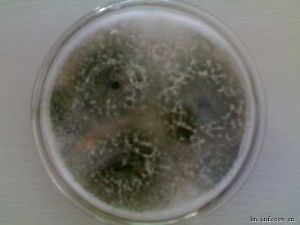
木黴菌

基本信息
木黴菌屬廣泛存在於不同環境條件下的土壤中。
木黴菌屬培養自19世紀中葉,人類對木黴菌已有了初步的認識,但直到上世紀60年代木黴菌的分類地位才得以確定。大多數木黴菌可產生多種對植物病原真菌、細菌及昆蟲具有拮抗作用的生物活性物質,比如細胞壁降解酶類和次級代謝產物,並能提高農作物的抗逆性,促進植物生長和提高農產品產量,因此被廣泛用於生物防治、生物肥料及土壤改良劑。由於化學農藥對環境的負面影響較為嚴重,所以對環境較為友好的生物農藥木黴菌受到了廣泛的關注。
形態特徵
其有性階段稱為肉座菌屬(Hypocrea)。菌絲透明有隔,分枝豐茂,分生孢子梗有對生或互生分枝,分枝上可再分枝,分枝頂端為小梗,瓶狀,束生、對生、互生或單生,由小梗生出分生孢子,多個分生孢子粘聚成球形的孢子頭。氣生菌絲的短側枝成為分生孢子梗,其上長出對生或互生分枝,並可再長出二級、三級分枝,分枝上又束生、對生、互生或單生瓶狀小梗,其末端產生近球形、橢圓形、圓筒形成倒卵形的分生孢子。分生孢子以黏液聚成球形或近球形的孢子頭。菌落伸展迅速,呈棉絮狀或緻密叢束狀,一般綠色,菌落表面常呈同心輪紋狀。一般腐生。
國內研究進度
國內對木黴菌生物防治方面的研究還局限於木黴菌對植物病原菌拮抗機理的初步分析,拮抗菌株的篩選,發酵條件的最佳化等。主要劑型為粉劑和可濕性粉劑。國內登記生產木黴菌製劑的企業雖然較少,但木黴菌製劑在市場上的銷售增長較為迅速,目前為止,木黴菌生防製劑已占據了真菌殺菌劑近一半的市場份額。
國外研究進度
國外木黴菌相關的研究與套用起步比較早,發展非常迅速,已有多種登記註冊的產品,例如木黴菌T22和T39。國外對木黴菌生防作用機制的研究也較為深入,不僅在木黴菌發酵過程控制方面具有先進的經驗和設備,並且對木黴菌所產生的具有生物防治活性的代謝產物的種類、化學結構及作用機理等方面也進行了較為詳細的研究。特別是近幾年,國外利用一些新的方法如蛋白質組學分析和基因報告系統等,研究植物、病原菌及木黴菌三方互作的關係。通過基因表達的差異分析進一步了解木黴菌生防作用的機理,從而為開發木黴菌新的生物防治技術提供理論支持。然而相關的研究在國內還未引起足夠的重視。
研究與套用
近些年,木黴菌的研究與套用得到了快速的發展。結合遺傳學、分子生物學、生物化學及生態學等研究方法,木黴菌及其代謝產物在促進植物生長,增加營養物質的吸收利用率,提高農作物的產量,以及增強對病害的防禦性方面勢必有更為廣闊的套用前景。特別是在倡導綠色農業的大背景下,木黴菌的大面積推廣套用已成為構建現代和高效的生物防治病蟲害體系中不可或缺的一部分。
隨著社會的進步,人們越來越深刻地認識到長期大量使用化學農藥對生態環境和人類健康的危害。生物防治可以有效地克服這些弊端,因而生物農藥越來越受到人們的重視。其中拮抗微生物在植病生防中的套用倍受人們關注。在目前已發現的拮抗微生物中,木黴菌(Trichodermaspp.)具有很好的生防活性。
防治特點
木黴菌系列產品在防治灰霉病上,主要有以下幾個防治特點值得同行業借鑑:
1、拮抗作用木黴菌通過產生小分子的抗生素和大分子的抗菌蛋白或胞壁降解酶類來抑制病原菌的生長、繁殖和侵染。木黴菌在抗生和菌寄生中,可產生幾丁質酶、β21,3葡聚糖酶、纖維素酶和蛋白酶來分解植物病原真菌的細胞壁或分泌葡萄糖苷酶等胞外酶來降解病原菌產生的抗生毒素。同時,木黴菌還分泌抗菌蛋白或裂解酶來抑制植物病原真菌的侵染。
2、競爭作用木黴菌可以通過快速生長和繁殖而奪取水分和養分、占有空間、消耗氧氣等,以至削弱和排除同一生境中的灰霉病病原物。
3、重寄生作用研究發現木黴菌會在特定環境裡形成腐霉對灰霉病菌具有重寄生作用,它進入寄主菌絲後形成大量的分枝和有性結構,因而能抑制葡萄灰霉病症狀的出現。
4、誘導抗性木黴菌可以誘導寄主植物產生防禦反應,不僅能直接抑制灰葡萄孢的生長和繁殖,而且能誘導作物產生自我防禦系統獲得抗病性。
5、促生作用經實驗人員發現,木黴菌在使用過程中,不僅能控制灰霉病的發生,而且能增加種子的萌發率、根和苗的長度以及植株的活力。